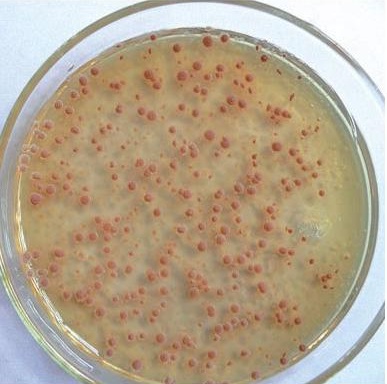
硝化菌種

生物處理效果差(低溫對微生物菌種危害性很大)
?行業(yè)動態(tài) ????|???? ?2021-07-29 17:20:06
溫度是影響細菌生長和代謝的重要環(huán)境條件。絕大多數(shù)微生物正常生長溫度為20~35℃。溫度主要是通過影響微生物細胞內(nèi)某些酶的活性而影響微生物的生長和代謝速率,進而影響污泥產(chǎn)率、污染物的去除效率和速率;溫度還會影響污染物降解途徑、中間產(chǎn)物的形成以及各種物質(zhì)在溶液中的溶解度,以及有可能影響到產(chǎn)氣量和成分等。低溫減弱了微生物體內(nèi)細胞質(zhì)的流動性,進而影響了物質(zhì)傳輸?shù)却x過程,并且普遍認(rèn)為低溫將會導(dǎo)致活性污泥的吸附性能和沉降性能下降,以及使微生物群落發(fā)生變化。低溫對微生物活性的抑制,不同于高溫帶來的毀滅性影響,其抑制作用通常是可恢復(fù)的。
硝化菌種
溫度對污水處理菌種的影響
污水處理微生物菌種低于5℃以下生長受到非常大抑制或者死亡,水溫在10-40℃范圍內(nèi)能夠正常生長繁殖,在10-15℃生長繁殖較緩慢,并隨著溫度增高而繁殖加快,25-37C最適宜生長繁殖,在碳源充足情況下(也就是有機質(zhì)豐富)時約20-30分鐘繁殖一代,超過48℃后生長繁殖受到抑制,但也能繁殖,超過50度復(fù)合菌種培養(yǎng)微生物繁殖受到很大抑制,最后污水發(fā)黑發(fā)臭死亡。
推薦閱讀:《低溫總氮降解菌 了解一下!》